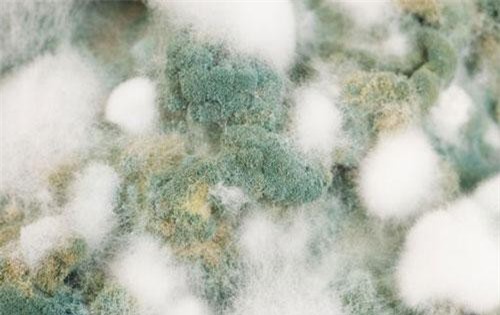
Sự nóng lên toàn cầu đang gắn liền với một dịch bệnh mới?

Tìm kiếm: Căn-bệnh-bí-ẩn
Dân số loài nhím biển tím đã tăng tới 10.000% trong vòng 5 năm, đe dọa nghiêm trọng sự cân bằng sinh thái ở những khu vực bờ biển phía tây nước Mỹ, đặc biệt là ở California.
Các nhân viên y tế đã phải dùng vải buộc chặt tay chân của một cậu bé 4,5 tuổi vào thanh giường để giữ cho cậu không gặp nhấm chính các bộ phận trên cơ thể mình….
Nhà tiên tri Vanga nổi tiếng với nhiều dự đoán chính xác đã được kiểm chứng. Bà Vanga đã đưa ra một số dự đoán về năm 2019, trong đó có tiên tri về cuộc xung đột quy mô lớn. Liệu tiên đoán của bà có trở thành sự thật.
Sự lây lan nhanh chóng một dạng nấm candida mới trên toàn thế giới có thể là do nhiệt độ tăng liên tục trên Trái đất trong nửa thế kỷ qua. Điều này cho thấy các dịch bệnh khác của bệnh nấm có thể đe dọa loài người.
Bị nhốt bên trong thể xác bất động suốt 12 năm, một người đã kể lại trải nghiệm kinh hoàng về cơn ác mộng tưởng chừng như không bao giờ dừng lại.
Mặc dù y học hiện là một trong những ngành nghề chuyên nghiệp mà khó có thể thay thế, nhưng vì cơ thể và cấu trúc não bộ của con người khá phức tạp, nên đôi khi các bác sĩ cũng không thể chẩn đoán ra căn bệnh đó rốt cuộc là bệnh gì.
Xuất hiện từ rất sớm nhưng cho đến giờ những căn bệnh kỳ lạ này vẫn chưa có phương pháp điều trị cụ thể.
Căn bệnh này khiến nạn nhân đau đớn và vẻ ngoài xấu xí. Trên khắp cơ thể xuất hiện nhiều mụn màu nâu đỏ giống như vỏ cây. Nếu nạn nhân không được điều trị kịp thời, những mụn này có thể phát triển thành ung thư da ác tính.
Chính phủ Canada thông báo sẽ rút một nửa số nhân viên ngoại giao tại Cuba sau khi thêm một trường hợp bị phát hiện gặp vấn đề về sức khỏe với các triệu chứng bí ẩn từng xảy ra với các nhà ngoại giao Mỹ trước đây tại Havana.
Có lẽ ai cũng sẽ bị ám ảnh mất vài ngày, vài tuần hoặc thậm chí vài tháng sau khi tìm hiểu về những căn bệnh kinh dị này.
Nguyên nhân của căn bệnh bí ẩn mà hàng loạt nhà ngoại giao Mỹ mắc phải trong một thời gian dài ở Cuba đã được lý giải.
Người mắc hội chứng Dancing Mania sẽ nhảy múa cho đến chết mà các bác sĩ không biết được vì sao họ nhảy.
Một căn bệnh kỳ lạ, khiến nhiều người phải bỏ mạng vì nó. Và giờ đây, nó đang tiếp tục xuất hiện ở những nơi bất ngờ nhất.
End of content
Không có tin nào tiếp theo